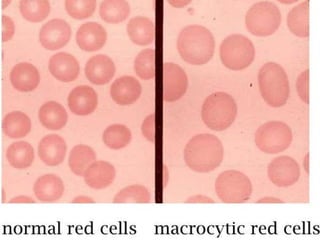

Anemia is a condition where the hemoglobin level or red blood cell count is lower than normal. It can be caused by blood loss, decreased red blood cell production, or increased red blood cell destruction. Globally, anemia affects over 1.6 billion people. Common symptoms include fatigue, weakness, and pale skin. Diagnosis involves blood tests to measure hemoglobin, red blood cell count, and other indicators. Treatment depends on the underlying cause but may involve iron supplementation, vitamin B12/folate, blood transfusions, or treating the primary disease.